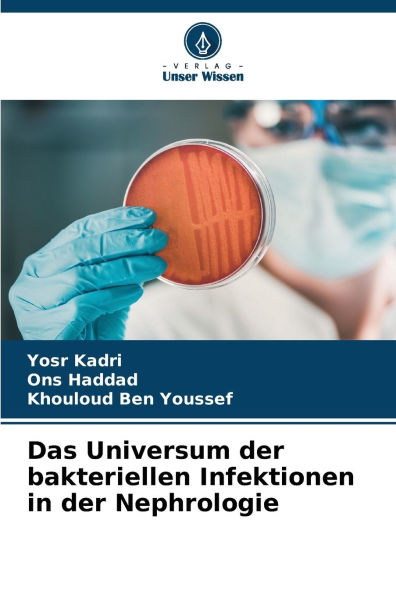
Das Universum der bakteriellen Infektionen in der Nephrologie

Home
Das Verbrechen Der Zauberei Crimen Magiae
Barnes and Noble
Loading Inventory...
Das Verbrechen Der Zauberei Crimen Magiae in Chattanooga, TN
Current price: $39.95

Barnes and Noble
Das Verbrechen Der Zauberei Crimen Magiae in Chattanooga, TN
Current price: $39.95
Loading Inventory...
Size: Hardcover
Das Verbrechen Der Zauberei Crimen Magiae
untersucht die Geschichte des Verbrechens der Zauberei. Geschrieben von Fritz Byloff und veröffentlicht im Jahr 1902, bietet dieses Buch einen detaillierten Einblick in die Verfolgung von Hexerei und Magie in der Geschichte, insbesondere im deutschsprachigen Raum. Es analysiert die sozialen, kulturellen und rechtlichen Aspekte, die zu Anklagen und Verurteilungen wegen Zauberei fÃ1/4hrten. Byloff beleuchtet die historischen Kontexte und Motive hinter den Hexenverfolgungen und bietet eine umfassende Analyse der damaligen Denkweise. Dieses Buch ist ein wertvolles Dokument fÃ1/4r Historiker und alle, die sich fÃ1/4r die Geschichte der Hexenverfolgung und ihre gesellschaftlichen Auswirkungen interessieren.
This work has been selected by scholars as being culturally important, and is part of the knowledge base of civilization as we know it. This work was reproduced from the original artifact, and remains as true to the original work as possible. Therefore, you will see the original copyright references, library stamps (as most of these works have been housed in our most important libraries around the world), and other notations in the work.
This work is in the public domain in the United States of America, and possibly other nations. Within the United States, you may freely copy and distribute this work, as no entity (individual or corporate) has a copyright on the body of the work.
As a reproduction of a historical artifact, this work may contain missing or blurred pages, poor pictures, errant marks, etc. Scholars believe, and we concur, that this work is important enough to be preserved, reproduced, and made generally available to the public. We appreciate your support of the preservation process, and thank you for being an important part of keeping this knowledge alive and relevant.
untersucht die Geschichte des Verbrechens der Zauberei. Geschrieben von Fritz Byloff und veröffentlicht im Jahr 1902, bietet dieses Buch einen detaillierten Einblick in die Verfolgung von Hexerei und Magie in der Geschichte, insbesondere im deutschsprachigen Raum. Es analysiert die sozialen, kulturellen und rechtlichen Aspekte, die zu Anklagen und Verurteilungen wegen Zauberei fÃ1/4hrten. Byloff beleuchtet die historischen Kontexte und Motive hinter den Hexenverfolgungen und bietet eine umfassende Analyse der damaligen Denkweise. Dieses Buch ist ein wertvolles Dokument fÃ1/4r Historiker und alle, die sich fÃ1/4r die Geschichte der Hexenverfolgung und ihre gesellschaftlichen Auswirkungen interessieren.
This work has been selected by scholars as being culturally important, and is part of the knowledge base of civilization as we know it. This work was reproduced from the original artifact, and remains as true to the original work as possible. Therefore, you will see the original copyright references, library stamps (as most of these works have been housed in our most important libraries around the world), and other notations in the work.
This work is in the public domain in the United States of America, and possibly other nations. Within the United States, you may freely copy and distribute this work, as no entity (individual or corporate) has a copyright on the body of the work.
As a reproduction of a historical artifact, this work may contain missing or blurred pages, poor pictures, errant marks, etc. Scholars believe, and we concur, that this work is important enough to be preserved, reproduced, and made generally available to the public. We appreciate your support of the preservation process, and thank you for being an important part of keeping this knowledge alive and relevant.
Das Verbrechen Der Zauberei Crimen Magiae
untersucht die Geschichte des Verbrechens der Zauberei. Geschrieben von Fritz Byloff und veröffentlicht im Jahr 1902, bietet dieses Buch einen detaillierten Einblick in die Verfolgung von Hexerei und Magie in der Geschichte, insbesondere im deutschsprachigen Raum. Es analysiert die sozialen, kulturellen und rechtlichen Aspekte, die zu Anklagen und Verurteilungen wegen Zauberei fÃ1/4hrten. Byloff beleuchtet die historischen Kontexte und Motive hinter den Hexenverfolgungen und bietet eine umfassende Analyse der damaligen Denkweise. Dieses Buch ist ein wertvolles Dokument fÃ1/4r Historiker und alle, die sich fÃ1/4r die Geschichte der Hexenverfolgung und ihre gesellschaftlichen Auswirkungen interessieren.
This work has been selected by scholars as being culturally important, and is part of the knowledge base of civilization as we know it. This work was reproduced from the original artifact, and remains as true to the original work as possible. Therefore, you will see the original copyright references, library stamps (as most of these works have been housed in our most important libraries around the world), and other notations in the work.
This work is in the public domain in the United States of America, and possibly other nations. Within the United States, you may freely copy and distribute this work, as no entity (individual or corporate) has a copyright on the body of the work.
As a reproduction of a historical artifact, this work may contain missing or blurred pages, poor pictures, errant marks, etc. Scholars believe, and we concur, that this work is important enough to be preserved, reproduced, and made generally available to the public. We appreciate your support of the preservation process, and thank you for being an important part of keeping this knowledge alive and relevant.
untersucht die Geschichte des Verbrechens der Zauberei. Geschrieben von Fritz Byloff und veröffentlicht im Jahr 1902, bietet dieses Buch einen detaillierten Einblick in die Verfolgung von Hexerei und Magie in der Geschichte, insbesondere im deutschsprachigen Raum. Es analysiert die sozialen, kulturellen und rechtlichen Aspekte, die zu Anklagen und Verurteilungen wegen Zauberei fÃ1/4hrten. Byloff beleuchtet die historischen Kontexte und Motive hinter den Hexenverfolgungen und bietet eine umfassende Analyse der damaligen Denkweise. Dieses Buch ist ein wertvolles Dokument fÃ1/4r Historiker und alle, die sich fÃ1/4r die Geschichte der Hexenverfolgung und ihre gesellschaftlichen Auswirkungen interessieren.
This work has been selected by scholars as being culturally important, and is part of the knowledge base of civilization as we know it. This work was reproduced from the original artifact, and remains as true to the original work as possible. Therefore, you will see the original copyright references, library stamps (as most of these works have been housed in our most important libraries around the world), and other notations in the work.
This work is in the public domain in the United States of America, and possibly other nations. Within the United States, you may freely copy and distribute this work, as no entity (individual or corporate) has a copyright on the body of the work.
As a reproduction of a historical artifact, this work may contain missing or blurred pages, poor pictures, errant marks, etc. Scholars believe, and we concur, that this work is important enough to be preserved, reproduced, and made generally available to the public. We appreciate your support of the preservation process, and thank you for being an important part of keeping this knowledge alive and relevant.